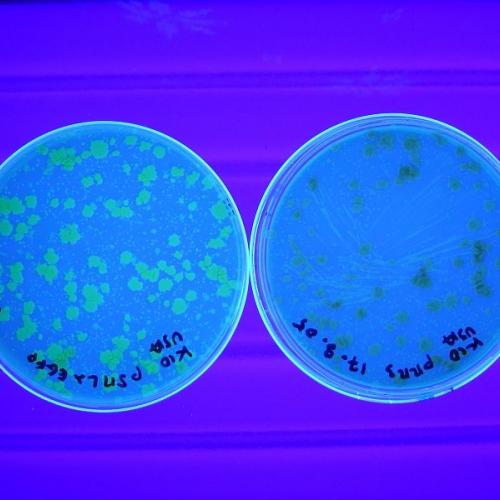

Les recherches du département Microbiologie et chaîne alimentaire
• développer la microbiologie pour les usages non alimentaires de la biomasse, des effluents et des déchets de la chaîne alimentaire ;
• améliorer la qualité et la sécurité sanitaire des aliments via les processus de transformations microbiologiques des aliments et via les recherches sur les risques microbiens associés ;
• contribuer au bien-être et à la santé des animaux, à la réduction des infections bactériennes et à la prévention des zoonoses microbiennes ;
• contribuer à la santé et au bien-être de l’être humain par la connaissance du microbiote intestinal et de ses interactions avec l’alimentation et avec la physiologie de l’hôte.

Les thématiques majeures du département MICA

Microbiologie pour une approche raisonnée des biotechnologies
Cette thématique associe des équipes travaillant en biologie des systèmes, en biologie de synthèse et en biotechnologies blanches et environnementales. Les activités dans ce domaine sont focalisées sur le fonctionnement et l'ingénierie des microorganismes et des communautés microbiennes, dans un contexte de bioéconomie (production et transformation de la biomasse). Le développement de la bioéconomie est incontournable pour faire face à l‘épuisement graduel des ressources fossiles et relever les enjeux environnementaux associés. Les enjeux dans ce domaine concernent d’une part l’extrapolation des bioprocédés de l’échelle du laboratoire à l’échelle industrielle et visent d’autre part à mieux comprendre les principes régissant les écosystèmes complexes et à évaluer la faisabilité de l’ingénierie écologique pour optimiser ou concevoir des systèmes biotechnologiques.
- Priorité 1 : ingénierie et conception des microorganismes, vers une meilleure intégration des procédés.
- Priorité 2 : définition des règles de fonctionnement des communautés microbiennes pour leur pilotage et le contrôle des bioprocédés.
Mots clefs : biologie prédictive, ingénierie métabolique et enzymatique, valorisation de la biomasse, bio-raffineries, design de souches, mécanismes d'adaptation, modélisation, contrôle, pilotage.

Microbiologie pour la qualité, la durabilité et la sureté des aliments
Cette thématique aborde les enjeux de la chaîne alimentaire en termes de sécurité sanitaire, de transformation et de préservation de l’aliment dans une démarche de durabilité. Les microorganismes sont des causes majeures d’altération et de risque sanitaire dans les aliments, et représentent des obstacles pour les évolutions des filières alimentaires, telles que les démarches sans additifs, les nouvelles formes de distribution et de consommation d’aliments, les besoins de santé et de sureté, la meilleure gestion des ressources. Les microorganismes sont par ailleurs une source de solutions pour améliorer la durabilité des systèmes alimentaires, notamment via l’utilisation des écosystèmes microbiens pour la production et la protection des aliments. En particulier, les aliments fermentés représentent une voie d’avenir, notamment en source d’innovations, comme la transformation de matières premières nouvelles, le développement de produits territorialisés et le développement d’aliments pour la santé.
- Priorité 1 : Les risques microbiens associés à de nouvelles contraintes, de nouvelles pratiques et de nouveaux produits.
- Priorité 2 : Assemblages des communautés microbiennes des aliments pour des fonctions d’intérêt.
- Priorité 3 : Les aliments « microbiens » (aliments fermentés prébiotiques, probiotiques, symbiotiques) comme leviers du bien-être et de la santé.
Mots clefs : altération des aliments, risques sanitaires, pathogènes, biotransformation, biopréservation, gestion des ressources, aliments fermentés, aliments pour la santé.

Microbiologie pour le maintien de la santé animale et humaine
Cette thématique aborde les enjeux de risques infectieux des élevages à l’homme d’une part, et de santé-bien être d’autre part, en étudiant les liens entre microbiotes, pathogènes et hôtes animaux et humain.
Les maladies métaboliques chez l’homme et infectieuses chez l’animal sont devenues en quelques décennies des enjeux sociétaux majeurs. Les premières mises en évidence de mécanismes associant richesse, composition du microbiote intestinal et paramètres clés de santé permettent de considérer les microbiotes (de l’intestin et d’autres organes) comme un réel levier pour la santé humaine et animale. D’une part, le microbiote possède la capacité à restreindre la croissance de certaines espèces pathogènes et des travaux combinant pathogène(s), microbiote et réponse de l'hôte doivent être approfondis pour donner jour à des alternatives inédites aux antibiotiques. D’autre part, les impacts des pratiques, conditions de vie, les modes de consommation alimentaire, sur les microbiotes en relation avec la santé, n’ont pas été suffisamment explorés.
- Priorité 1 : Comprendre les interactions chez l’hôte.
- Priorité 2 : Diagnostic et nouvelles approches thérapeutiques.
- Priorité 3 : Évaluer l'impact de l'environnement sur le microbiote et la santé de l’hôte.
- Priorité 4 : Décrypter la dynamique des flux microbiens.
Mots clefs : santé, bien être, microbiote, métagénome, pathogènes, pathobiome, réponse de l'hôte, écologie, flux de gènes, virulence, antibiorésistance, alternatives aux antibiotiques, diagnostic, pronostic, prébiotiques, probiotiques.
Les 5 grands objectifs du département MICA
- Objectif 1 : Relever les défis de la biologie de synthèse
- Objectif 2 : Les fermentations alimentaires : innovations et nouveaux défis de l’alimentation
- Objectif 3 : Limiter l’apparition de résistances aux anti-infectieux (antibiotiques)
- Objectif 4 : Favoriser la symbiose microbiote - homme
- Objectif 5 : MICA et les acteurs non marchands
Le métaprogramme HOLOFLUX : "Holobiontes et flux microbiens au sein des systèmes agri-alimentaires"
Les métaprogrammes constituent un dispositif d’animation et de programmation scientifique sur un nombre restreint de sujets nécessitant des approches systémiques et interdisciplinaires pour répondre à nos défis scientifiques et sociétaux.
Le département MICA pilote un programme de recherches interdisciplinaires, transversal aux départements scientifiques d'INRAE. Lancé en 2019, le métaprogramme HOLOFLUX a pour objectif d'accéder à une meilleure connaissance, d'une part des interactions entre microbiotes et hôtes, au sein des holobiontes, et d'autre part des flux de microorganismes entre les holobiontes et dans l’ensemble du système agri-alimentaire ; l'objectif étant de pouvoir les maîtriser et les utiliser comme leviers à des fins de performance, de durabilité et de préservation de la santé humaine, animale et végétale.

Humains, animaux, plantes, nous sommes tous des holobiontes, c'est-à-dire des êtres vivants avec leurs cohortes de microorganismes étroitement associés. Le concept d’holobionte nourrit des travaux scientifiques de plus en plus nombreux allant de l'étude des écosystèmes environnementaux, animaux ou végétaux, jusqu'à celle de l’immunité, de la nutrition et de la santé humaine.
Voir aussi : Métaprogrammes : l’interdisciplinarité pour relever nos défis
